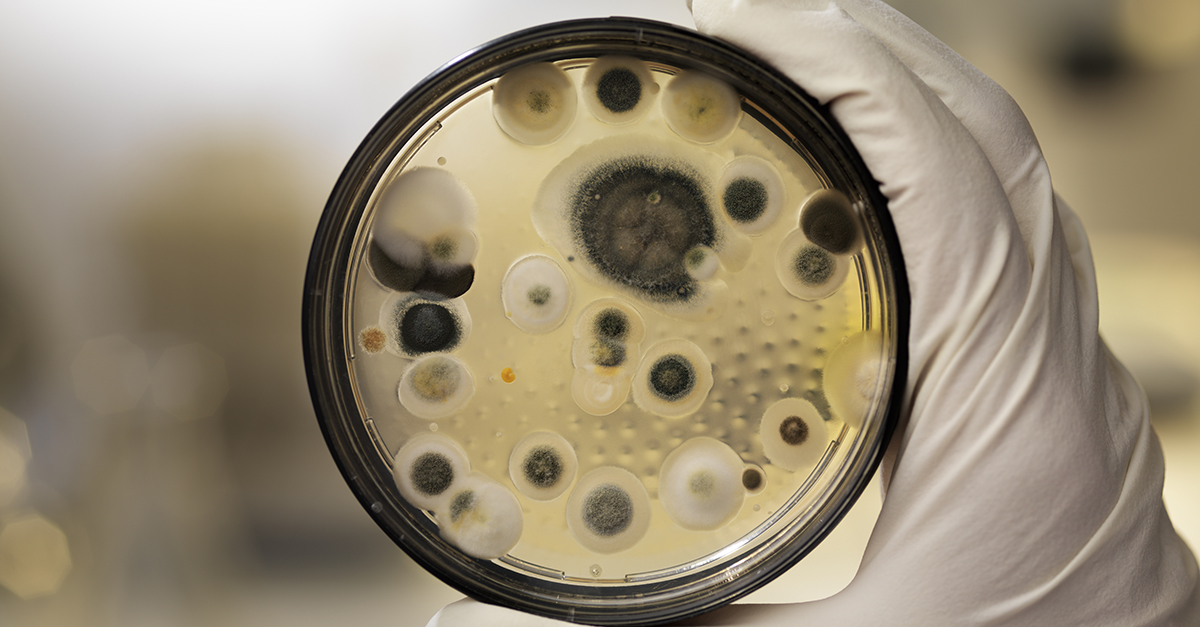
Expertise Matters for Mold Assessment

Post-pandemic, COVID-19 has transformed not only our cleaning practices, but also our perception of the air we breathe. Today, facility managers, building services contractors, and medical professionals recognize that mold assessments are no longer simple checklists; they serve as a crucial defense for occupant health.
“We are at a time when even the U.S. federal government is recognizing this, and it is imperative that professionals bring themselves up to speed with the proper education and resources to address the relationship between the indoor environment and the health of people,” said Doug Hoffman, founder and executive director of the National Organization of Remediators and Microbial Inspectors (NORMI), a not-for-profit training and certification organization for indoor air quality professionals.
From standards to science
For decades, mold work focused on visible patch jobs and post-flood cleanups. But experts now emphasize that health impacts extend far beyond what the eye can see. Mold fragments, spores, and
microbial volatile organic compounds (mVOCs) can affect sensitive individuals even when the walls look clean. Moreover, the industry is shifting from appearance-based cleaning to science-based, health-driven remediation. That shift is embodied in the NORMI Level Four Protocol, an international protocol that sets a higher bar for assessing, documenting, and managing mold issues in buildings. This represents a new era of accountability with remediation contractors expected to provide measurable, health-focused outcomes, not just good-enough cleanups The NORMI Level Four Protocol not only aligns with existing standards such as the Institute of Inspection, Cleaning, and Remediation Certification’s (IICRC) “Standard and Reference Guide for Professional Mold Remediation” (S520); it goes even further. The protocol incorporates medical insights, baseline sampling, and post-remediation verification to prove that cleanup efforts improve indoor environments.
Testing for mold is imperative when dealing with Condition 2 environments because you’re dealing with invisible contaminants. IICRC S520 describes a Condition 2 environment as an indoor
environment primarily contaminated with settled spores or fungal fragments that were dispersed from a source of actual mold growth, which is either visible or hidden.
Human health risks
One of NORMI’s achievements is the formation of the NORMI Medical Advisory Board as part of the remediation industry. Chaired by Dr. Andrew Heyman, a leading expert in environmental health, this board is helping to bridge the gap between medical science and remediation practices.
NORMI’s aim is to ensure that mold remediation methods not only remove visible mold but also address the following hidden contaminants that can cause illness in people.
- Spores: Reproductive cells that can trigger asthma and allergies.
- mVOCs: Gases that indicate active mold growth.
- Mycotoxins: Toxic compounds affecting neurological and immune health.
- Beta-glucans and fragments: Molecules that can inflame the respiratory system.
Mold assessor skills
A successful microbial assessment determines the sources, locations, and extent of microbial growth in a building and understands the conditions that caused microbial growth. Qualified mold assessors are part detective, part scientist, and part health advocate. Their core competencies include:
- Identifying mold growth (visible and hidden).
- Tracing moisture sources and mapping affected areas.
- Measuring moisture and psychrometric data (temperature, humidity, dew point).
- Designing sampling plans that combine air, surface, dust, and mVOC testing.
- Interpreting lab results against industry and NORMI interpretation charts.
- Delivering written reports with site-specific findings and recommendations.
To be a NORMI professional, you need the skills to perform an assessment where suspect microbial growth exists to determine whether a remediation protocol or a biotoxin
decontamination is needed—or, perhaps, both. These skills include:
- Client intake: Do you know how to ask the right questions to understand why services are needed?
- Building information: Do you have the skills to gather key details—such as building size, HVAC system features, and areas of suspected mold growth—and request mechanical
drawings when needed? - Assessment options: Can you clearly explain sampling types, project pricing, remediation schedules, and deliverable characteristics to set realistic expectations?
- Contract process: Do you know how to prepare and review a contract that protects both you and the client, and act as a trusted resource even before work begins?
- Assessment preparation: Are you trained to select the right diagnostic tools, paperwork, and resources before arriving on-site?
- Payment collection: Do you understand how to manage client agreements and ensure payment before leaving the job site?
- Assessment execution: Do you know how to conduct structured interviews, exterior and interior inspections, and develop a sampling strategy using NORMI Level 4 Protocol guidelines
- Client communication: Can you set realistic timelines for sample processing, reporting, and unforeseen delays to manage expectations?
- Sample handling: Do know how to complete chain of custody forms correctly and ship samples to certified labs, especially for legal cases?
- Data interpretation: Are you skilled at interpreting lab results against NORMI professional practices to determine if sanitization or remediation is required?
- Report writing: Do you know how to prepare a mold assessment report (MAR) that meets NORMI standards and offer a mold remediation protocol (MRP) when needed?
- Protocol development: Can you incorporate the final NORMI Sanitization Protocol and post-project testing requirements into your reports?
- Project closure: Do you know how to verify project completion and apply for a NORMI Certificate of Sanitization™ to finalize the process?
A holistic assessment
NORMI’s Level Four Protocol helps mold remediators meet these assessment challenges. Unlike standard mold assessment and removal practices, the Level Four Protocol examines the entire environment, not just one room or surface. A systemic issue requires a holistic solution.
Using the Level Four Protocol, Certified NORMI professionals can conduct a thorough assessment and implement a comprehensive whole-building decontamination plan that genuinely supports the healing and well-being of the people who live or work in them.
Assessors use a sampling plan based on the NORMI Level Four Protocol to establish a baseline before remediation and to confirm success afterward. The plan involves:
- Air samples using spore traps.
- Surface samples using swabs, tapes, and adenosine triphosphate (ATP) meters.
- Dust sampling with HERTSMI-2 to detect species linked to health effects.
- Microbial VOC testing to detect gases produced by actively growing mold.
Mold assessment today goes beyond just a technical task—it’s a vital public health service. Mold assessors now prioritize creating healthier indoor environments and enhancing medical and building science understanding, rather than simply measuring spores.
NORMI’s partnerships with medical experts and its new NORMIPro Management National Service Provider Network directly enable data from assessments to support doctors and patients.